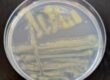
flavobacterium columnare kolonien auf anacker ordal

Die Haltung von Reptilien in menschlicher Obhut geschieht häufig mit dem Ziel, die gepflegte Art auch zu vermehren. Eine Grundvoraussetzung für die Zucht ist dabei die Kenntnis über das Ge-schlecht der eigenen Tiere. Zusätzlich ist dieses Wissen notwendig, weil es bei gleichgeschlechtlichen Individuen vieler Arten, spätestens ab Eintritt der Geschlechtsreife, zu territorialem Verhalten kommen kann, das sich im schlimmsten Fall in aggressiven Auseinandersetzungen äußert. Zwar gibt es auch bei vielen Reptilien, und auch bei zahlreichen Schlangen, einen deutlichen Geschlechtsdimorphismus, dieser besteht allerdings nur in Ausnahmefällen bei juvenilen Tieren, da er sich im Regelfall erst im Laufe der Zeit herausbildet. Bei vielen Arten erreicht er seine volle Ausprägung frühestens mit der Geschlechtsreife (Abb. 1). Ein prominentes Beispiel sind die Anakondas (Gattung Eunectes), bei denen adulte Weibchen um ein Vielfaches größer werden als die Männchen. Ein weiteres Beispiel ist die Tempelotter (Tropidolaemus wagleri), bei der neben einem Geschlechtsdimorphismus auch ein Geschlechtsdichromatismus, also ein geschlechtsspezifischer Unterschied in Färbung und Zeichnung besteht.
Während die Geschlechtsbestimmung bei adulten Individuen vieler Spezies vergleichsweise einfach ist, wird es bei subadulten oder juvenilen Tieren zur Herausforderung. Dabei ist gerade die korrekte Bestimmung von Schlüpflingen besonders wichtig, da die Abgabe an neue Halter eben meist bereits in diesem Alter erfolgt.
Es gibt eine Reihe manueller Methoden der Geschlechtsbestimmung, die ihrerseits häufig Nachteile haben.
1. Popping
Das sogenannte Popping bezeichnet ein künstliches Hervorstülpen der Hemipenes männlicher Schlangen aus den Hemipenistaschen (Abb. 2). Diese Methode hat den Nachteil, dass sie häufig nur bei sehr jungen Schlangen anwendbar ist, weil sich der Hemipenis bei älteren Tieren nicht mehr hervorstülpen lässt. Zusätzlich besteht eine nicht unerhebliche Gefahr von Verletzungen im Bereich der Wirbelsäule durch Abknicken des Schwanzes und Druckausübung direkt distal der Kloake. Des Weiteren besteht hier immer die Gefahr der Fehlbestimmung, sodass eigentliche Männchen als Weibchen fehlinterpretiert werden, wenn ein Hervorstülpen des Hemipenis misslingt.
2. Sondieren
Das Sondieren bezeichnet das Einführen einer Metallsonde in die Hemipenis- bzw. Hemiklitoristaschen unmittelbar distal der Kloake. Die Eindringtiefe der Sonde wird dabei in der Anzahl von Subcaudalschuppen gemessen, welche sie passiert. Die tieferen Hemipenistaschen männlicher Schlangen erlauben dabei ein tieferes Eindringen. Der größte Nachteil ist hierbei, dass ein Sondieren sehr kleiner Schlangen schlicht nicht möglich ist, weil ein Verletzungsrisiko im Sinne des Durchstoßens der Hemiklitoris der Weibchen besteht (Abb. 3). Auch birgt hier immer das Risiko einer Fehlbestimmung, und zwar in beide Richtungen.
3. Adspektion
Bestimmte Merkmale können ohne weitere Manipulation einen Hinweis auf das Geschlecht von Schlangen geben. Dazu zählen beispielsweise die Schwanzform oder sichtbare Geschlechtsmerkmale, z. B. in Form von Hemipenistaschen am Natternhemd (Abb. 4). Diese Methoden erfordern einerseits viel Erfahrung und sind gleichzeitig sehr unsicher, weshalb sie nur unter größtem Vorbehalt angewendet werden sollten.
-
Abb. 1: Geschlechtsdimorphismus bei der Steppennatter (Elaphe dione), Männchen oben, Weibchen unten
Bildquelle: Gregor Geisler
-
Abb. 2: Hervorgestülpter Hemipenis bei einer juvenilen Archelaphe bella chapaensis
Bildquelle: Gregor Geisler
-
Abb. 3: Die Schlüpflinge vieler Arten sollten wegen des hohen Verletzungsrisikos nicht sondiert werden
Bildquelle: Gregor Geisler
-
Abb. 4: Am Natternhemd adulter Schlangen lassen sich manchmal die Hemipenistaschen erkennen
Bildquelle: Gregor Geisler
-
Abb. 5: In der PCR wird ein Genabschnitt auf dem W-Chromosom der Weibchen amplifiziert, was sich anschließend auch auf dem Gel darstellen lässt
Bildquelle: Gregor Geisler
Wegen der vielen Nachteile der klassischen Methoden, haben wir eine molekularbiologische Methode etabliert, die eine zuverlässige Geschlechtsbestimmung vieler Spezies erlaubt. Dabei werden bestimmte Gene auf dem W-Chromosom weiblicher Schlangen nachgewiesen (Abb. 5). Als Probenmaterial sind Häutungen, Schleimhauttupfer oder EDTA-Blut geeignet. Die Vorteile sind eindeutig: Einerseits kann eine Geschlechtsbestimmung völlig altersunabhängig durchgeführt werden, andererseits besteht keine Verletzungsgefahr. Die Probengewinnung ist sehr einfach und daher für Schlangenhalter unproblematisch.
Wir konnten unsere Methode bereits bei über 60 Schlangenarten erfolgreich anwenden und bauen unser Angebot im weiteren Verlauf stetig aus. Die genetische Geschlechtsbestimmung bieten wir bis jetzt für Vipern, Grubenottern und für die meisten Nattern an. Alle häufig gehaltenen Arten wie Kornnatter, Königsnatter oder Hakennasennatter können sicher bestimmt werden. Für Boas und Pythons arbeiten wir derzeit an einer separaten Methode, um auch hier in Zukunft einen genetischen Test zur Geschlechtsbestimmung anzubieten.
Fazit
Die Geschlechtsbestimmung bei Schlangen, ins-besondere Schlüpflingen, ist lange eine Herausforderung gewesen. Mit dem genetischen Test gibt es nun eine ungefährliche und sichere Alternative zu den althergebrachten Methoden.
Gregor Geisler